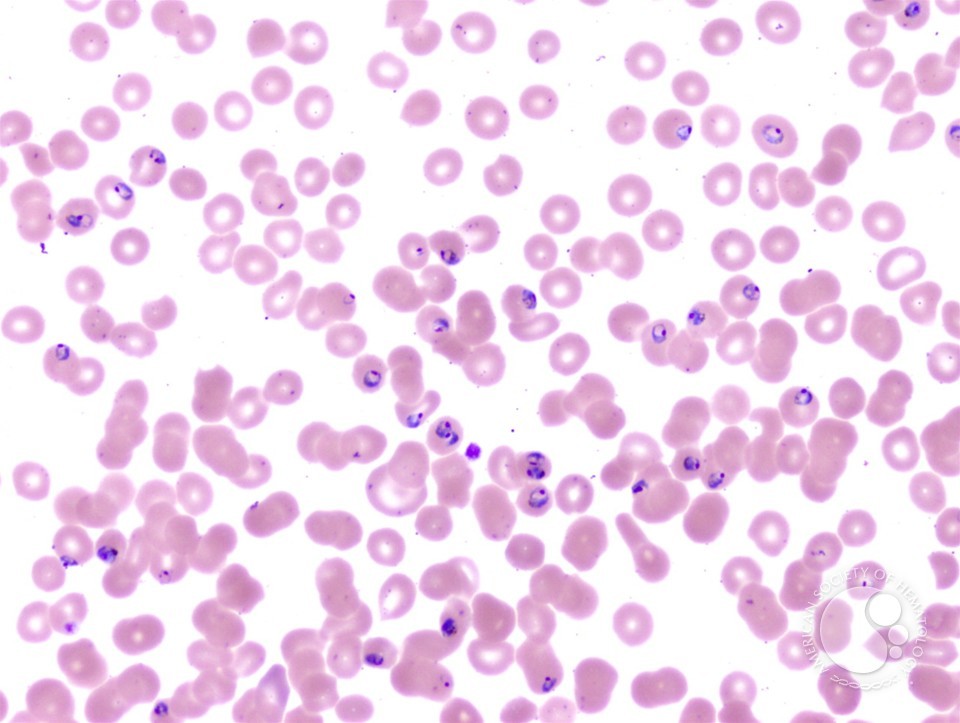

Kingdom?
Phylum?
Genus species?
Phases?
Motility?
Host?
Infected by?
Reserviors?
Symptoms?

Protista
amoeba
Giardia lamblia
Trophozoite
Flagella
Host- humans
Infected by: Fecal oral route
Reserviors- food, water, fecal matter
Symptoms: Diarrhea, dehydration
Kingdom?
Phylum?
Genus species?
Name large green structure?
Black dots on structure?
The main structure of a mushroom is called?
The stalk of a mushroom is called?
Reproductive stage?

Fungi
Phylum? Basidiomycota
Genus species? Coprinus
Large structure- Basidia
Black dots- basidosphores
Main mushroom structure- Basidiocarp
Stalk- Stipe
Sexual, no known asexual stage
Kingdom?
Phylum?
Species?
Black dots c? stalk?
reproduction stage?

Fungi
Phylum- ascomyota
Species- aspergillus
Structures- black dots-conidia, stalk- conidiophore
Asexual reproduction
Kingdom?
Phylum?
Species?
C?
stalks are called?
Sexual phase?

Fungi
Phylum- ascomyota
species- penicillium
c- Conidia
stalk- conidiophore
Asexual
Naegleri fowleri is transmitted in which way?
A opportunistic pathogen transmitted via pond or lake water with pathogen when forced up nasal passages.
Kingdom
Phylum?
Species?
Reproductive stage?
Stalk is called?
Head is called?
What is in the head?

Fungi
Phylum- Zygomycota
Species- Rhizopus
Asexual reproduction
stalk- sporangiophore
Head- Sporangium
In the head- Sporangiospores
Genus species?
Phase?

Balantidium coli
Cyst
Kingdom?
Phylum?
Genus species?
Motility?
Infected by?
Reservior?
Symptoms?
Definitive host?
Intermediate host?
Protista
Phylum- sporozoa
Plasmodium falciparum
No motility
Infected by- Anapheles mesquito
Reservior- Mesquito salivary glands, human blood and liver.
Chills fever
Definitive- Mesquito
Intermediate- Human
Genus species?
Structures?

Taenia solium “Pork tapeworm”
Proglottids, eggs in the Gravid proglottids
Naegleri fowleri
motility?
Reservior?
Host?
Symptoms?
Genus species
Pseudopods
Soil and water
Host- humans
Fever, severe headache, coma, death
Kingdom?
Phylum?
Genus species?
Infected by?
Reservior?
Host?
Symptoms?

Animalae
Nematoda / Round worm
Enterobius vermicularis “pin worm”
Infected by- Fecal oral route
Reservior? feces
Host? Humans
Symptoms? perianal pruritis
Kingdom?
Phylum?
Genus species?
Infected by?
Host?
Symptoms?

Animalae
Nematoda
Ascaris lumbricoides (no slide)
Infected by Fecal oral route
Host-Humans
Symptoms- Malnutrition
Kingdom?
Phylum?
Species?
Structure?
Inside structure?

Fungi
Phylum- Ascomyota
species-penicillium
Structure- cleistothecium
Inside Ascus with ascospores
Toxoplasma gondii
Infected by?
Definitive host?
Intermediate host?
Reserviors?
Symptoms?
The Genus species
Fecal-oral route
Definitive- Cat
Intermediate- Rodent
Cat feces
Fatigue, muscle aches
Kingdom?
Phylum?
Name?
Structure?
Reproductive stage?
Inside?

Fungi
Phylum- Ascomyota
Name- Peziza
Structure- Apothecium (Asocarp)
Reproductive stage- sexual
Inside- Ascus with ascospores
Kingdom?
Phylum?
Genus species?
Infected by?
Host?
Symptoms?

Animalae
Nematoda/round worm
Trichinella spiralis
Infected by- Ingestion of undercooked meat
Host- carnivorous mammals
Symptoms? Muscle pain
Kingdom?
Genus species?
Phase?
Motility?
Infected by?
Reservior?
Symptoms?

Protista
Balantidium coli
Trophozoite phase
Moves by Cilia
Infected by- Fecal oral route
Reservior- Food, water
Symptoms? Diarrhea
Kingdom?
phylum?
Genus species?
Motility?
Found?
Infected by?
Reserviors?
Symptoms?
Intermediate host?
Difinitive host?

Protista
Flagellates
Trypanosoma brucei
Flagella
Found in the blood
Infected by- Tsctse fly
Reserviors? Humans, The fly
Symptoms? Headache, fever, anemia
Intermediate host? tsctse fly
difinitive host- human
Kingdom?
Phylum?
Genus species?
Infected by?
Difinitive host?
Intermediate host?
Symptoms?

K- Animalae
P- platyhelminthes
GS- Fasciola hepatica “Liver fluke”
Infected by- Ingested aquatic vegetation
Difinitive host- Mammals
Intermediate host- snail
Symptoms? Jaundice
Kingdom?
Phylum?
Species genus?
Infected by?
Difinitive host?
Intermediate host?
Symptoms?
Locate structures

Animalae
Platyhelminthes
Taenia solium “Pork tapeworm”
Infected? Undercooked pork eaten
Difinitive host? Pig
Intermediate host- Human
Symptoms? Not severe
Image- Scolex, Hooks
Kindom?
Phylum?
Genus species?
Motility?
Infected by?
Reservior?
Symptoms?

Protista
flagellates
Trichomonas vaginalis
Moves by flagella
I-Sexual intercourse
R- Humans
S- irritation, inflammation
Kingdom?
Phylum?
Genus species?
Moltility?
Infected by?
Reserviors?
Symptoms?

Protista
amoeba
Entamoeba histolytica
Moves by pseudopods
Infected- Fecal oral route
Reserviors- food water
symptoms- lose stool, fever, abdominal pain
Kingdom?
Phylum?
Genus species?
Inside the structure?
Reproductive stage?

Fungi
Phylum- Ascomycota
Venturia
Type- Perithecium
Inside- Ascus with ascospores
sexual
Name the structure
Kingdom?
Phylum?

Zygosporangium
Fungi
Zygomycota



